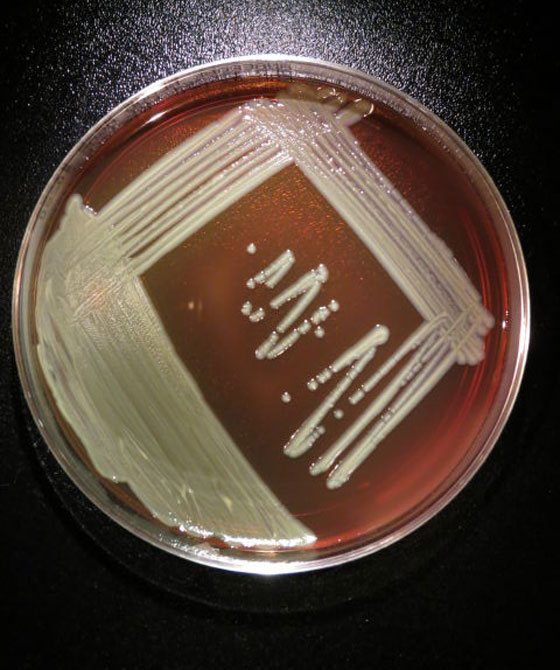

منذ نوفمبر/ تشرين الثاني الماضي، يعاني سكان ولاية وسكونسن الأميركية من عدوى بكتيرية غامضة تسمى "إليزابيث كنغيا" تنتقل عبر الدم، إذ أسفرت عن إصابة نحو 54 شخصا توفي منهم 15 لاحقا متأثرين بأعراض هذا المرض الغامض. ويقول نائب مدير مركز مكافحة الأمراض والوقاية بويسكونسن، ميشيل بيل، إن "المرض ينتشر بشكل كبير في نحو 12 مدينة بالولاية".
ويعكف مسؤولون بالصحة المحلية وفي المراكز الأميركية لمكافحة الأمراض والوقاية منها على الوقوف على أسباب العدوى التي أصابت من هم فوق 65 عاما من العمر ومعظمهم في جنوب شرق وجنوب الولاية. وتعد العدوى البكتيرية "إليزابيث كنغيا" عضوية الشكل، اكتشفتها عالمة الأحياء الدقيقة الأميركية إليزابيث كنغ عام 1959، ومن بين أعراضها ارتفاع درجة الحرارة وصعوبة التنفس والقشعريرة والتهاب الأنسجة الخلوية الضامة، فيما يحتاج تأكيد الإصابة إلى إجراء اختبارات بالمختبر.
من جانبها، ذكرت إدارة الخدمات الصحية في وسكونسن أن مسؤولي الصحة لا يعرفون كيف بدأت الإصابات، لكنهم يتعاونون مع 8 من محققي المراكز الأميركية الصحية لتحديد مصدر العدوى. وأضافت أن المسؤولين لم يحسموا بصورة قاطعة إن كانت هذه الإصابة أسهمت أو تسببت في وفاة الضحايا على الرغم من رصد إصابات إيجابية بالبكتيريا.